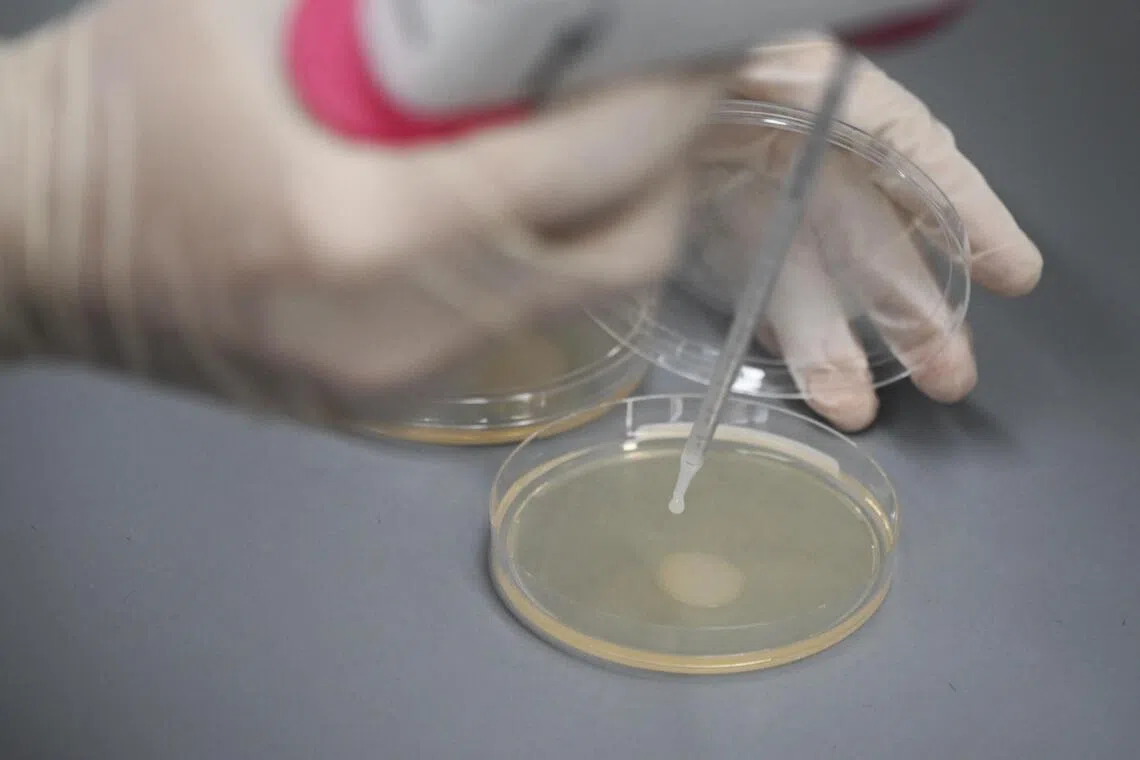

How SFA ensures mooncakes are safe to eat ahead of the Mid-Autumn Festival
Sign up now: Get ST's newsletters delivered to your inbox

During routine checks on businesses that make mooncakes for sale, SFA officers also inspect the food production facilities, such as the condition of and the cleanliness of the equipment, among other things.
ST PHOTO: BRIAN TEO
SINGAPORE – The Mid-Autumn Festival, which will be celebrated on Oct 6 in 2025, is usually marked with an explosion of colour, from showy lanterns to mooncakes that come in a dizzying array of colours and flavours.
But to ensure these tasty pastries are safe to eat during the annual celebration of the end of the autumn harvest, food scientists from the Singapore Food Agency (SFA) work in a much less variegated environment.
On Sept 24, The Straits Times had a behind-the-scenes glimpse into the sterile laboratory where SFA conducts tests to ensure that mooncakes for sale are free from pathogens that can cause people to be sick.
At the SFA National Centre for Food Science laboratory in Jurong East, food scientists in white lab coats first unpacked food samples and prepared them for testing.
The samples were obtained by SFA during its routine checks on food businesses that make mooncakes for sale.
During these checks, SFA officers inspect the food production facilities, such as the condition and cleanliness of the equipment. They also check expiry dates of food products and conduct visual inspections on whether the facility is clean and free of pests like cockroaches.
From Aug 18 to Sept 5, SFA inspected about 20 local mooncake manufacturers, which is about half of the manufacturers here. The agency also tests for potential contaminants in imported mooncakes.
SFA said on its website that given the wide variety of ingredients used in traditional and snowskin mooncakes, hazards such as microbiological pathogens may be introduced if the mooncakes are not manufactured or stored properly.
The importance of food safety has come to the fore following recent mass food poisoning incidents. In July 2024, for example, some 171 people at ByteDance were affected with food poisoning after consuming lunches prepared by catering company Yunhaiyao.

An SFA officer collecting samples for food safety checks.
ST PHOTO: BRIAN TEO
At the laboratory, microbiological tests are performed to screen for potential contaminants such as Escherichia coli (E. coli) and salmonella.
Such testing can be done in two ways – one measures the amount of bacteria in a sample, while the other tests for a pathogen’s presence.
Quantitative tests, which test for the amount of bacteria, are typically used on bacteria such as E. coli to make sure that their numbers are below allowed limits.
Under the food regulations set out in Singapore’s Sale of Food Act, the amount of E. coli of any strain detected in any ready-to-eat food must be less than 100 colony-forming units per gram for solid food, or per millilitre for liquid food.
Meanwhile, qualitative tests are usually used to check whether bacterial pathogens such as salmonella are present in the food items. SFA has a zero-tolerance policy for such pathogens, which means that the bacteria should not be found in the food item at all.
Mooncake samples are subject to both types of tests.
In the lab, Dr Ivan Zwe took about half of a yellow, durian-flavoured snowskin mooncake and added a solution to dilute it. This turned the mixture into a liquid form, making it easier for testing.
Then, he threw the mixture into a mechanical “stomach”.
Dr Zwe, who is a food scientist in the Food Science Rapid Response Department at SFA’s National Centre for Food Science, said: “Just like our stomach, the machine will churn the sample and it will homogenise it by mechanically mixing the food sample with the solution.”
Homogenising a mixture ensures the whole mixture has an even spread of the compounds, making the testing more consistent.

At an SFA lab, food scientist Ivan Zwe took about half of a yellow, durian-flavoured snowskin mooncake and added a solution to dilute it, before putting the mixture into a mechanical “stomach” to homogenise the mixture.
ST PHOTO: KUA CHEE SIONG
The homogenised sample was then spread on a plate with agar. This is a jelly-like substance which serves as a nutrient-rich medium that provides an ideal environment for bacterial growth in laboratory settings.
When bacteria are spread on agar plates, they multiply and form visible colonies that can be observed, counted and analysed, said Dr Zwe.
The homogenised sample was then spread on a plate with agar, which serves as a nutrient-rich medium that provides an ideal environment for bacterial growth in laboratory settings.
ST PHOTO: KUA CHEE SIONG
This technique also allows scientists to determine bacterial counts to assess contamination levels, he added.
The samples will then be placed in an incubator, which provides the optimal temperature of about 37 deg C for the bacteria to grow at a maximum rate.
“If I leave these plates out on the bench, it will probably take about two or three days before they start growing properly into colonies. But if I put them at the optimal temperature of 37 deg C, it will grow in 24 hours, which is the fastest growth rate,” he said.
At the same time, the incubator also doubles as a colony counter – it has a camera for counting and analysing the bacterial colonies on agar plates.

The incubator also doubles as a colony counter – it has a camera for counting and analysing the bacterial colonies on agar plates.
ST PHOTO: KUA CHEE SIONG
It captures high-resolution images of the plates and uses software algorithms to automatically identify, count and measure colonies based on their size, shape and colour characteristics, said Dr Zwe. This makes testing more efficient and less laborious.
The system can also store digital records of the plates and generate reports, which is useful for processing large numbers of samples efficiently and maintaining documentation of bacterial counts, he added.
After 24 hours, by running the final bacteria count through mathematical algorithms, food scientists will be able to find out the amount of bacteria like E. coli, if any, present in the original food samples and evaluate whether they are safe for consumption.
To test for the presence of bacteria such as salmonella, the food scientists mix an enrichment broth with the food samples.
The homogenised samples are then placed in another incubator for 24 hours to let the bacteria, if any, grow.
The scientists check for the presence of bacteria by looking for specific genetic sequences of harmful bacteria such as salmonella or Listeria monocytogenes.
Polymerase chain reaction (PCR) machines, for example, look for specific sequences of DNA. This process is akin to how Covid-19 is detected as the test looks for the genetic material of the virus in a swab sample.
For samples that are flagged by the PCR process, there will be follow-up tests to isolate and identify the bacterial organism in question, said Dr Zwe.

For samples that are flagged by the polymerase chain reaction process, there will be follow-up tests to isolate and identify the bacterial organism in question, said Dr Ivan Zwe.
ST PHOTO: KUA CHEE SIONG
If any food samples are found unsuitable for consumption, they will be tested again to confirm the presence of the bacteria. This could trigger follow-up actions from SFA that may include recalling the food item.
From 2022 to 2024, SFA said it conducted 77 food recalls for safety reasons, such as the detection of physical, chemical, microbiological contamination, as well as non-compliance reasons such as undeclared allergens.
Emphasising that food safety inspections are an important measure to ensure safe preparation and handling of food to safeguard public health, SFA said: “These inspections enable early detection and rectification of procedures and practices that may pose risks to food safety.”
How to ensure your mooncakes are safe to eat:
Buying mooncakes:
Buy mooncakes from reputable sellers that observe good food-handling practices, such as wearing gloves or using tongs when handling mooncakes.
Check that the mooncakes are packaged in a manner that prevents them from being exposed to the environment.
For snowskin mooncakes, ensure that they are kept at low temperatures in their packaging, such as using dry ice packs or a styrofoam box after purchase.
Preparing mooncakes:
Ensure that the ingredients used are purchased from reputable sources.
Observe good hand hygiene practices to prevent cross-contamination. Wash your hands before handling the ingredients.
Ensure food-contact surfaces such as table tops and equipment in direct contact with food are kept clean and sanitary.
Store flour in a cool and dry place to minimise the growth of mould.
Storing and consuming mooncakes:
Pay attention to any storage instructions and consume mooncakes by the expiry dates indicated on the package.
Traditional mooncakes that are not in sealed packaging should be stored in an airtight container and kept in a cool and dry place.
Snowskin mooncakes should be stored in refrigerated conditions as soon as possible after purchase.
Ice cream mooncakes should be stored in the freezer and consumed as soon as possible upon opening. Do not refreeze mooncakes after they have been thawed.
Do not consume any mooncakes that are discoloured or smell unpleasant.
Source: SFA



